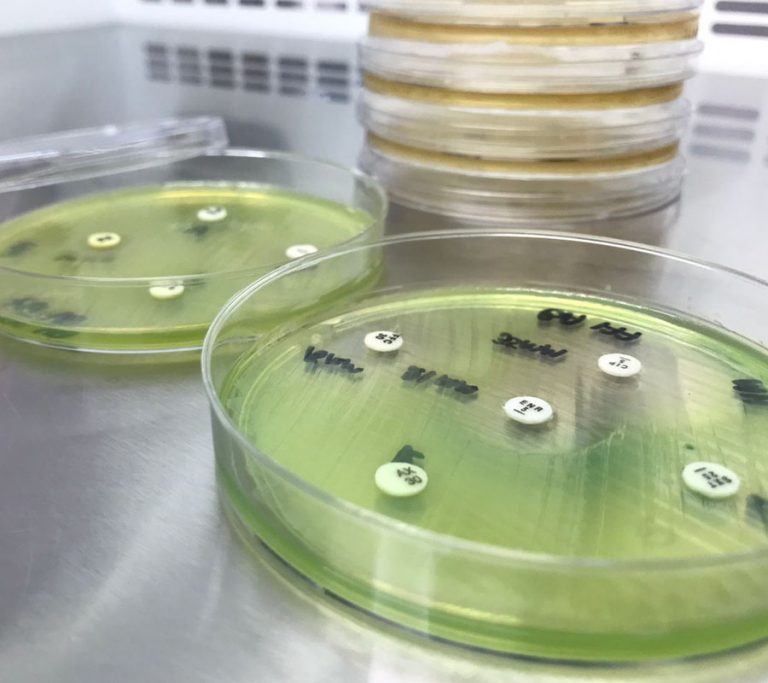
Bacteriología

Contamos con equipos de última tecnología para el procesamiento de muestras e identificación de microorganismos, asegurando control de calidad, trazabilidad y proporcionando resultados con mayor confiabilidad y precisión.
Ofrecemos pruebas individuales para el diagnóstico de enfermedades producidas por bacterias, hongos y otros microorganismos; así como estudios de sensibilidad a fármacos (antibiogramas).

Realizamos el estudio que permite comprobar la presencia de anticuerpos específicos en la sangre o el aumento del título de anticuerpos.

Análisis bromatológico en alimentos de consumo humano, alimentos balanceados para animales y materias primas

Te ofrecemos determinación de vida útil de productos, concentración mínima inhibitoria, prueba de poderes para desinfectantes, luminometría e identificación y serotipificación de microorganismos por PCR en tiempo real

Realizadas por personal idóneo y especialista con años de experiencia en manipulación de alimentos, toma de muestras, principios metrológicos, entre otras. (Presencial o virtual).
Las instalaciones del laboratorio están construidas con áreas físicamente distribuidas de tal forma que no afecte los ensayos y se evite la contaminación cruzada.
Controlamos las condiciones ambientales para garantizar resultados confiables a través de termómetros, termohigrómetros, deshumidificadores y datalogger.
La calidad y confiabilidad son nuestras prioridades, adquirimos equipos con los mejores proveedores y aplicamos un plan metrológico riguroso para garantizar que brinden resultados certeros según los métodos y técnicas analíticas aplicadas.
En Quinolab hacemos homogenización mecánica evitando sesgos por procesos manuales.
Beneficio: Equipo para la preparación homogénea de las muestras.

Identificamos patógenos con resultados cualitativos mediante técnica de fotoluminiscencia en diferentes matrices de alimentos.
Beneficio: Análisis en 24 horas.

Toma de muestras en superficies para detectar la presencia de materia orgánica y garantizar la eficiencia del desinfectante.
Beneficio: Resultado inmediato sobre la eficiencia de la limpieza en tus superficies.

Análisis bromatológicos proximales de la calidad de las materias primas (macro ingredientes) destinadas para el consumo animal.
Beneficios: Resultado inmediato.

Descripción: te brindamos resultados cuantitativos para el diagnóstico veterinario en microorganismos patógenos.
Beneficio: Análisis en 24 horas

Descripción: Análisis: Newcastle (NVD), Bronquitis Infecciosa (IBV), Gumboro Biocheck (IBD), Mycoplasma Gallisepticum (Mg), Mycoplasma Synoviae (Ms), Encefalomielitis (AE), Reovirus (REO), Anemia Infecciosa Aviar (CAV), Laringotraqueitis aviar (ILT).
Beneficio: Te ayudamos a conocer la respuesta vacunal en tus aves o si enfrentan enfermedades que no sean bacterias cultivables.

Descripción: Aislando desde la colonia podemos realizar serotipificación de Salmonella para que tomes medidas correctivas específicas de acuerdo a la normativa de tu sector.
Beneficio: si tu resultado de Salmonella es positivo podemos identificar el serotipo en 8 horas.
Te ayudamos a controlar la calidad del agua con análisis fisicoquímicos basados en métodos normalizados (Estándar Methods) cuantificando pH, conductividad, turbiedad y sólidos totales en cumplimiento a la resolución 2115 y los demás requisitos para aguas potables y envasadas.
Beneficio: resultados inmediatos de análisis de aguas para cumplir con la resolución 2115 de 2007
 Informes estadísticos y de tendencia
Informes estadísticos y de tendencia
 Recolección y Transporte de muestras
Recolección y Transporte de muestras
 Acceso a asesorías puntuales
Acceso a asesorías puntuales
 Capacitación en toma de muestras
Capacitación en toma de muestras



